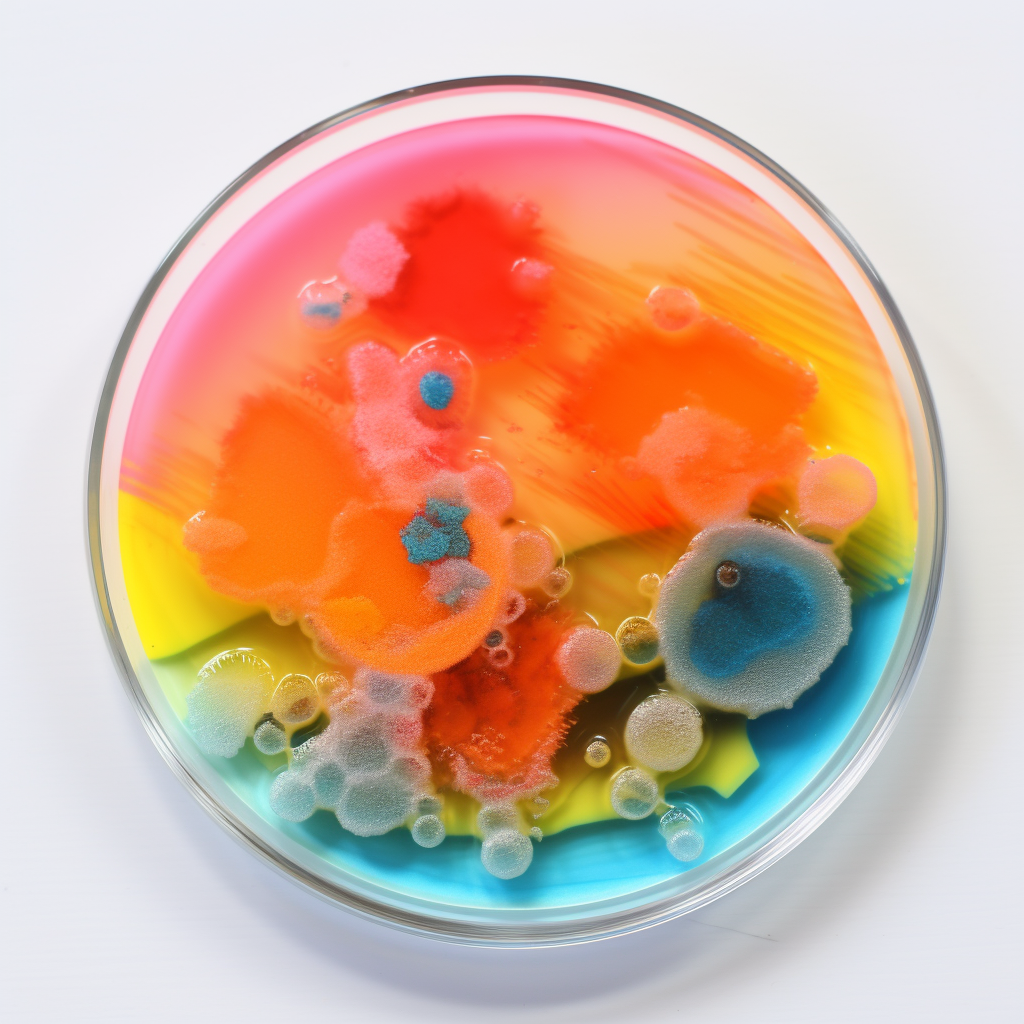

Bacteria
Definition
Bacteria is a plural noun that refers to a large group of single-celled, microscopic organisms that exist in various environments. Bacteria can be both beneficial and harmful, playing key roles in ecosystems, human health, and disease.
Parts of Speech
- Noun (plural)
Pronunciation
American English
- IPA Pronunciation: /bækˈtɪriə/
- Respelling: bak-TEER-ee-uh
British English
- IPA Pronunciation: /bækˈtɪəriə/
- Respelling: bak-TEER-ee-uh
Etymology
The word "bacteria" originates from the Greek word "bakterion," meaning "small staff," referring to the shape of the first bacteria observed. It was first used in English in the 19th century, with "bacterium" as the singular form.
Derivatives
- Bacterium (noun, singular)
- Bacterial (adjective)
- Bacteriology (noun)
- Bactericide (noun)
- Antibacterial (adjective)
Synonyms
- Microorganism
- Microbe
- Germ
Antonyms
- None
Usage
The noun "bacteria" is used to describe microscopic, single-celled organisms found in various environments. For example, "Some bacteria are essential for digestion," or "The infection was caused by harmful bacteria."
Related Terms
- Virus: A different type of microorganism that infects living cells.
- Prokaryote: A type of cell without a defined nucleus, which includes bacteria.
- Antibiotic: A medication used to kill or inhibit bacteria.
Detailed Definitions
Noun (plural)
- Microscopic, single-celled organisms: Refers to unicellular organisms that can inhabit various environments, including soil, water, and living organisms.
- Example: "Certain bacteria aid in nitrogen fixation in plants."
- Organisms involved in health and disease: Bacteria play roles in ecosystems and the human body, contributing to processes like digestion but also causing infections.
- Example: "The doctor prescribed antibiotics to combat the bacteria causing the infection."
bacteria

🇨🇳 Mandarin (Simplified Chinese)
- 细菌 (xìjūn)
- IPA Pronunciation: /ɕi˥˩ t͡ɕyn˥˩/
- Respelling: shee-joon
🇮🇳 Hindi
- जीवाणु (jīvāṇu)
- IPA Pronunciation: /d͡ʒiː.ʋaː.ɳu/
- Respelling: jee-vaanu
🇪🇸 Spanish
- Bacteria
- IPA Pronunciation: /bakˈte.ɾja/
- Respelling: bak-TEH-ree-ah
🇫🇷 French
- Bactérie
- IPA Pronunciation: /bak.tʁi/
- Respelling: bak-tree
🇦🇪 Modern Standard Arabic
- بكتيريا (baktīryā)
- IPA Pronunciation: /bak.tiː.riː.aː/
- Respelling: bak-teer-yaa
🇧🇩 Bengali
- ব্যাকটেরিয়া (byākṭeriẏā)
- IPA Pronunciation: /bʌktɛria/
- Respelling: bakt-eh-ri-aa
🇷🇺 Russian
- Бактерия (Bakteriya)
- IPA Pronunciation: /bɐkˈtʲerʲɪjə/
- Respelling: bak-TEH-ree-ya
🇵🇹 Portuguese
- Bactéria
- IPA Pronunciation: /bɐkˈtɛ.ɾi.ɐ/
- Respelling: bak-TEH-ree-ah
🇮🇩 Indonesian
- Bakteri
- IPA Pronunciation: /bakˈteri/
- Respelling: bak-TEH-ree
🇩🇪 German
- Bakterium (singular), Bakterien (plural)
- IPA Pronunciation: /bakˈteː.ri.ʊm/, /bakˈteː.ri.ən/
- Respelling: bak-TEH-ree-um, bak-TEH-ree-en
🇯🇵 Japanese
- 細菌 (Saikin)
- IPA Pronunciation: /sa.i.kin/
- Respelling: sai-kin
🇻🇳 Vietnamese
- Vi khuẩn
- IPA Pronunciation: /vi˧˥ xwan˨˩/
- Respelling: vee khwan
🇰🇷 Korean
- 세균 (segyun)
- IPA Pronunciation: /sʰe.gʲun/
- Respelling: seh-gyoon
🇹🇷 Turkish
- Bakteri
- IPA Pronunciation: /bɑk'te.ri/
- Respelling: bahk-TEH-ree
🇵🇰 Urdu
- جراثیم (jarāṣīm)
- IPA Pronunciation: /d͡ʒəˈraː.ʃiːm/
- Respelling: juh-RAA-sheem





